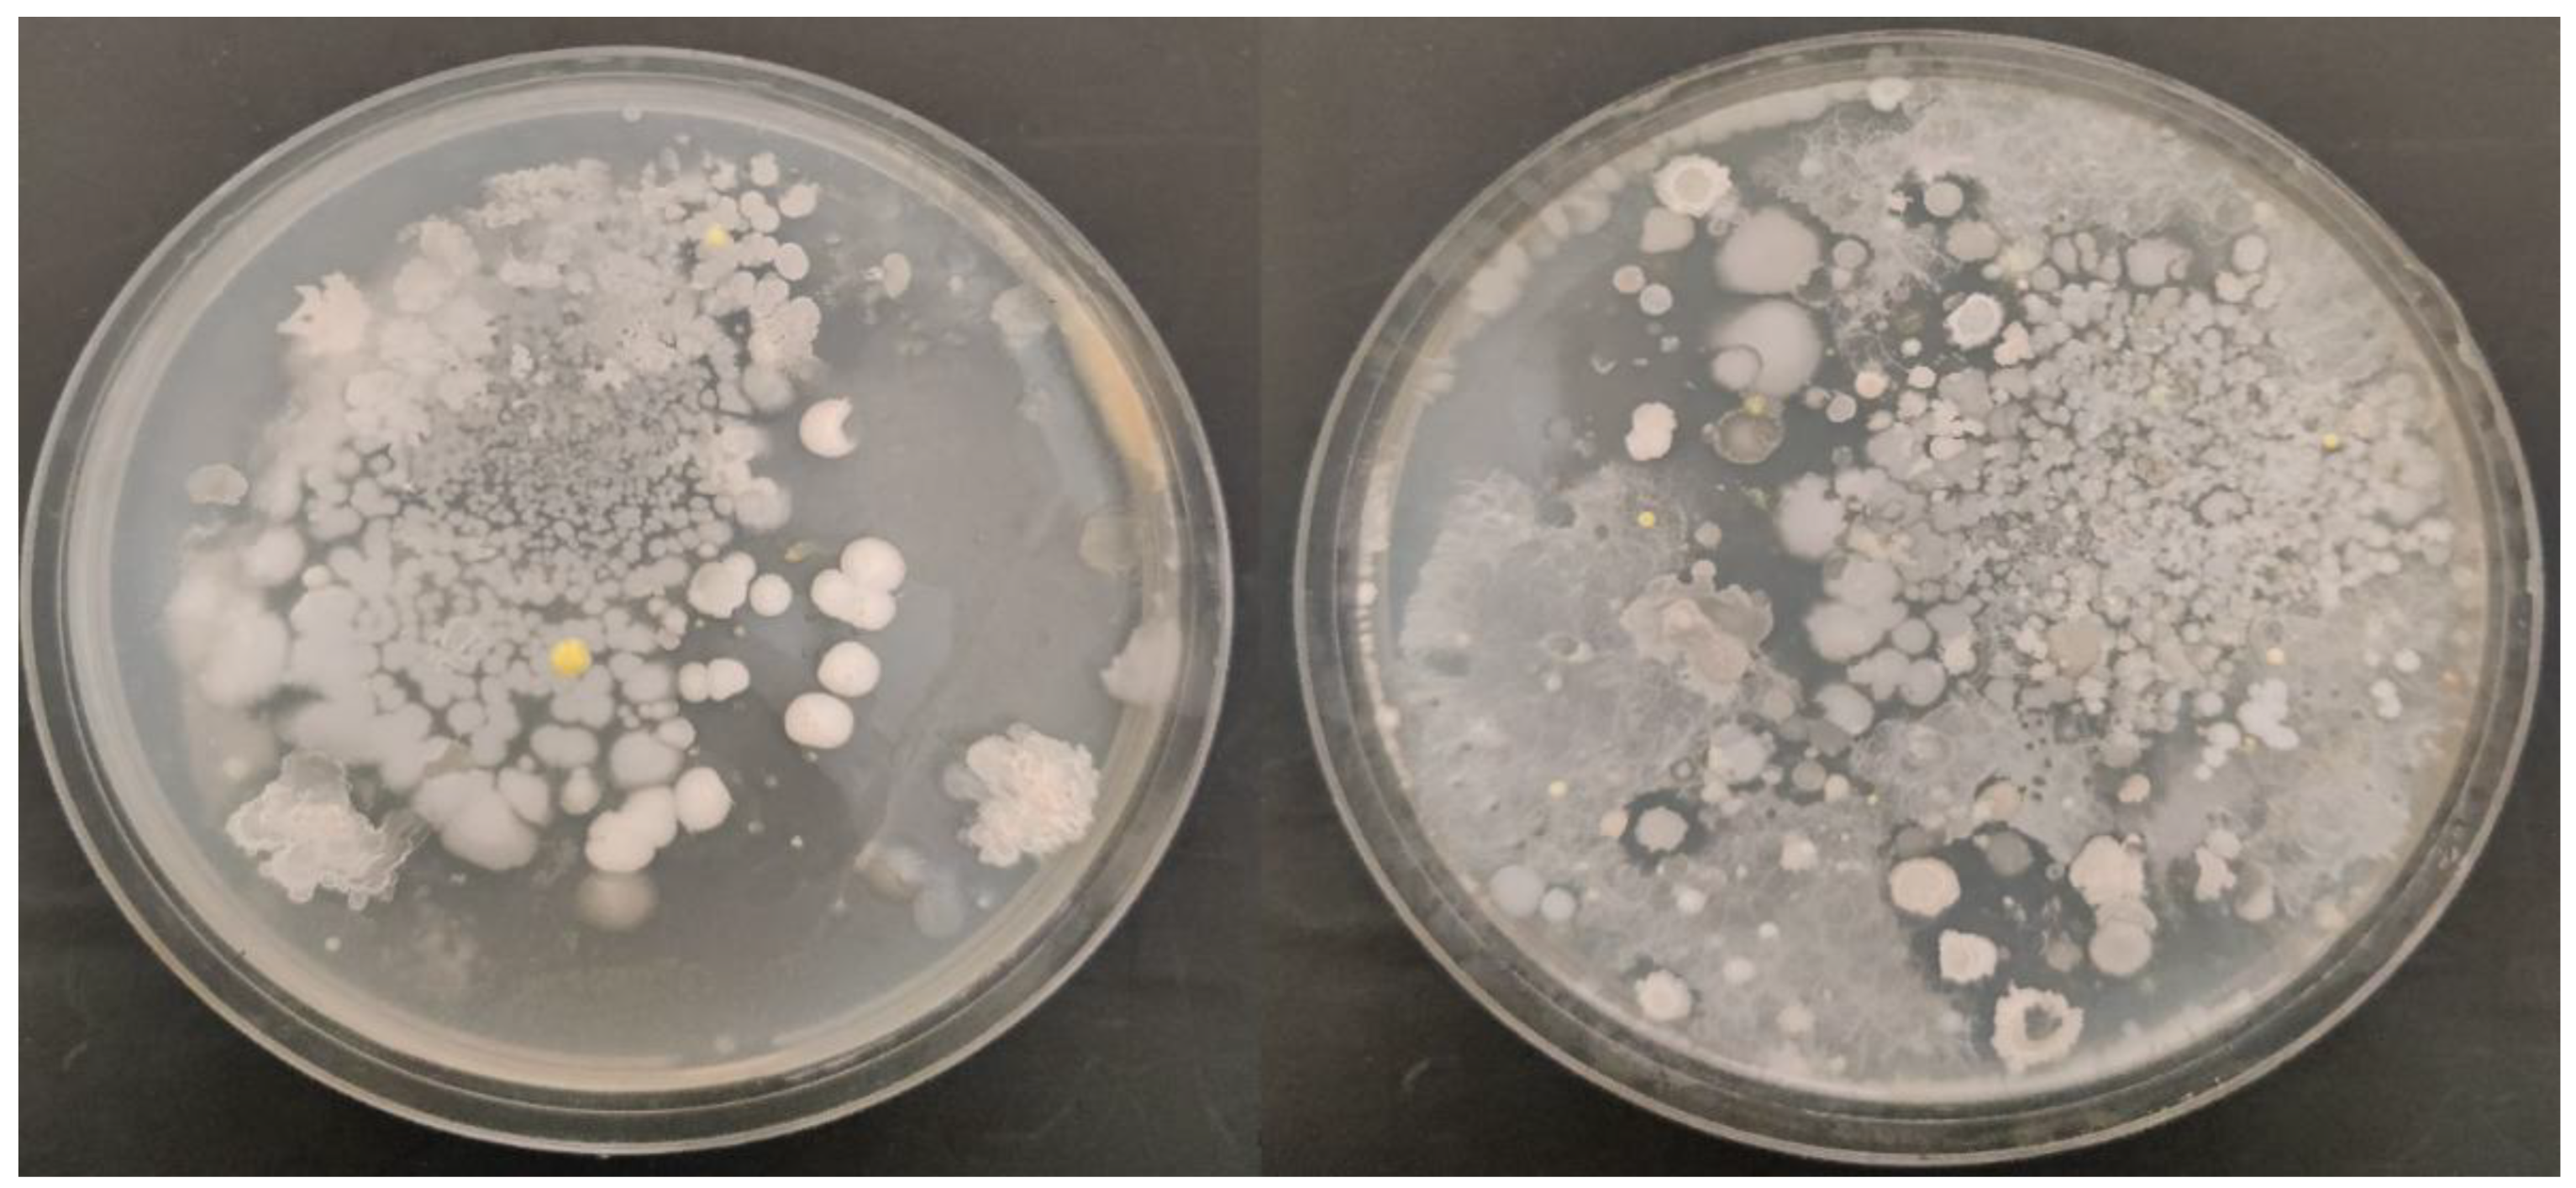
Preprints 170892 g001
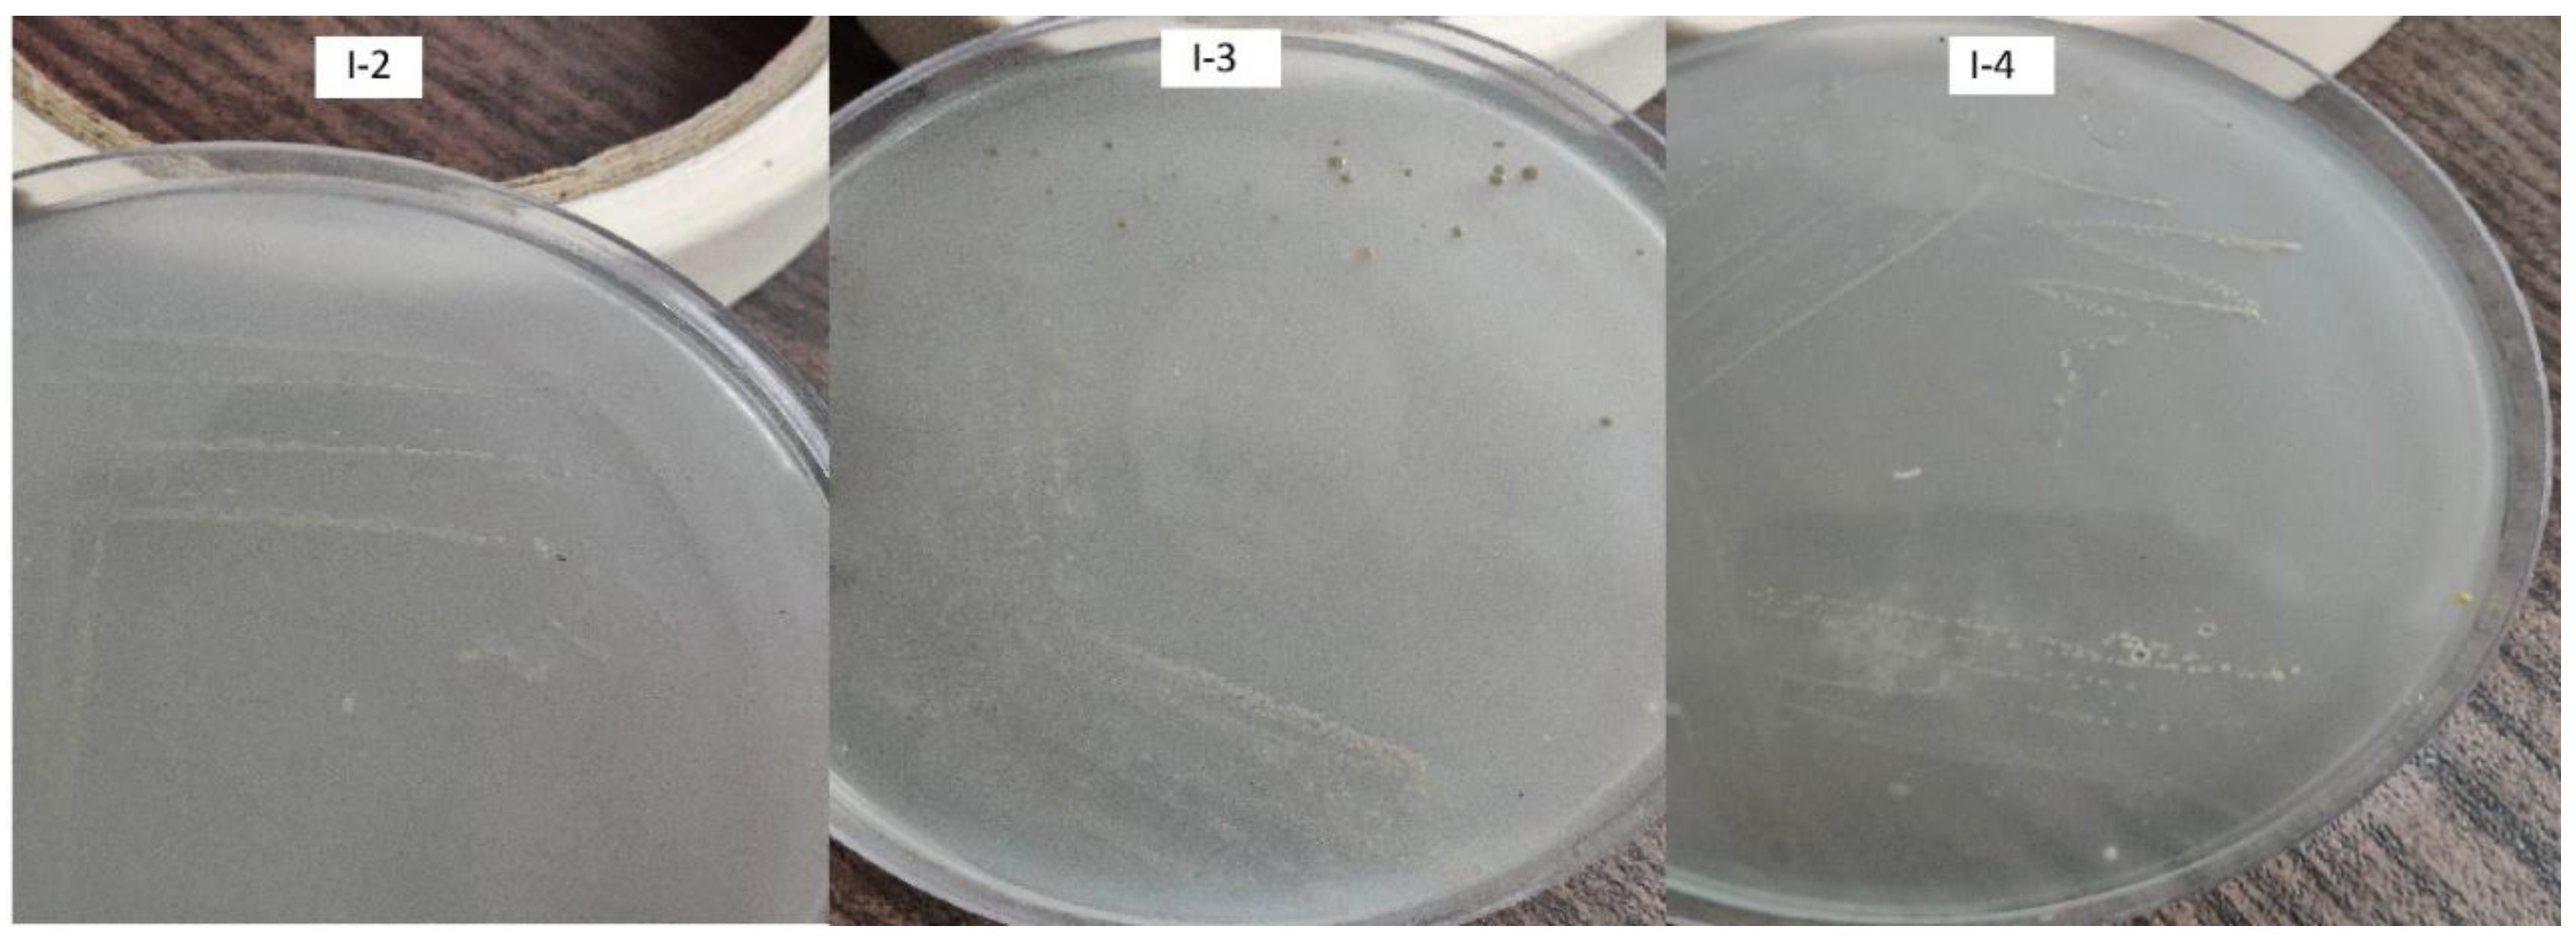
Preprints 170892 g003
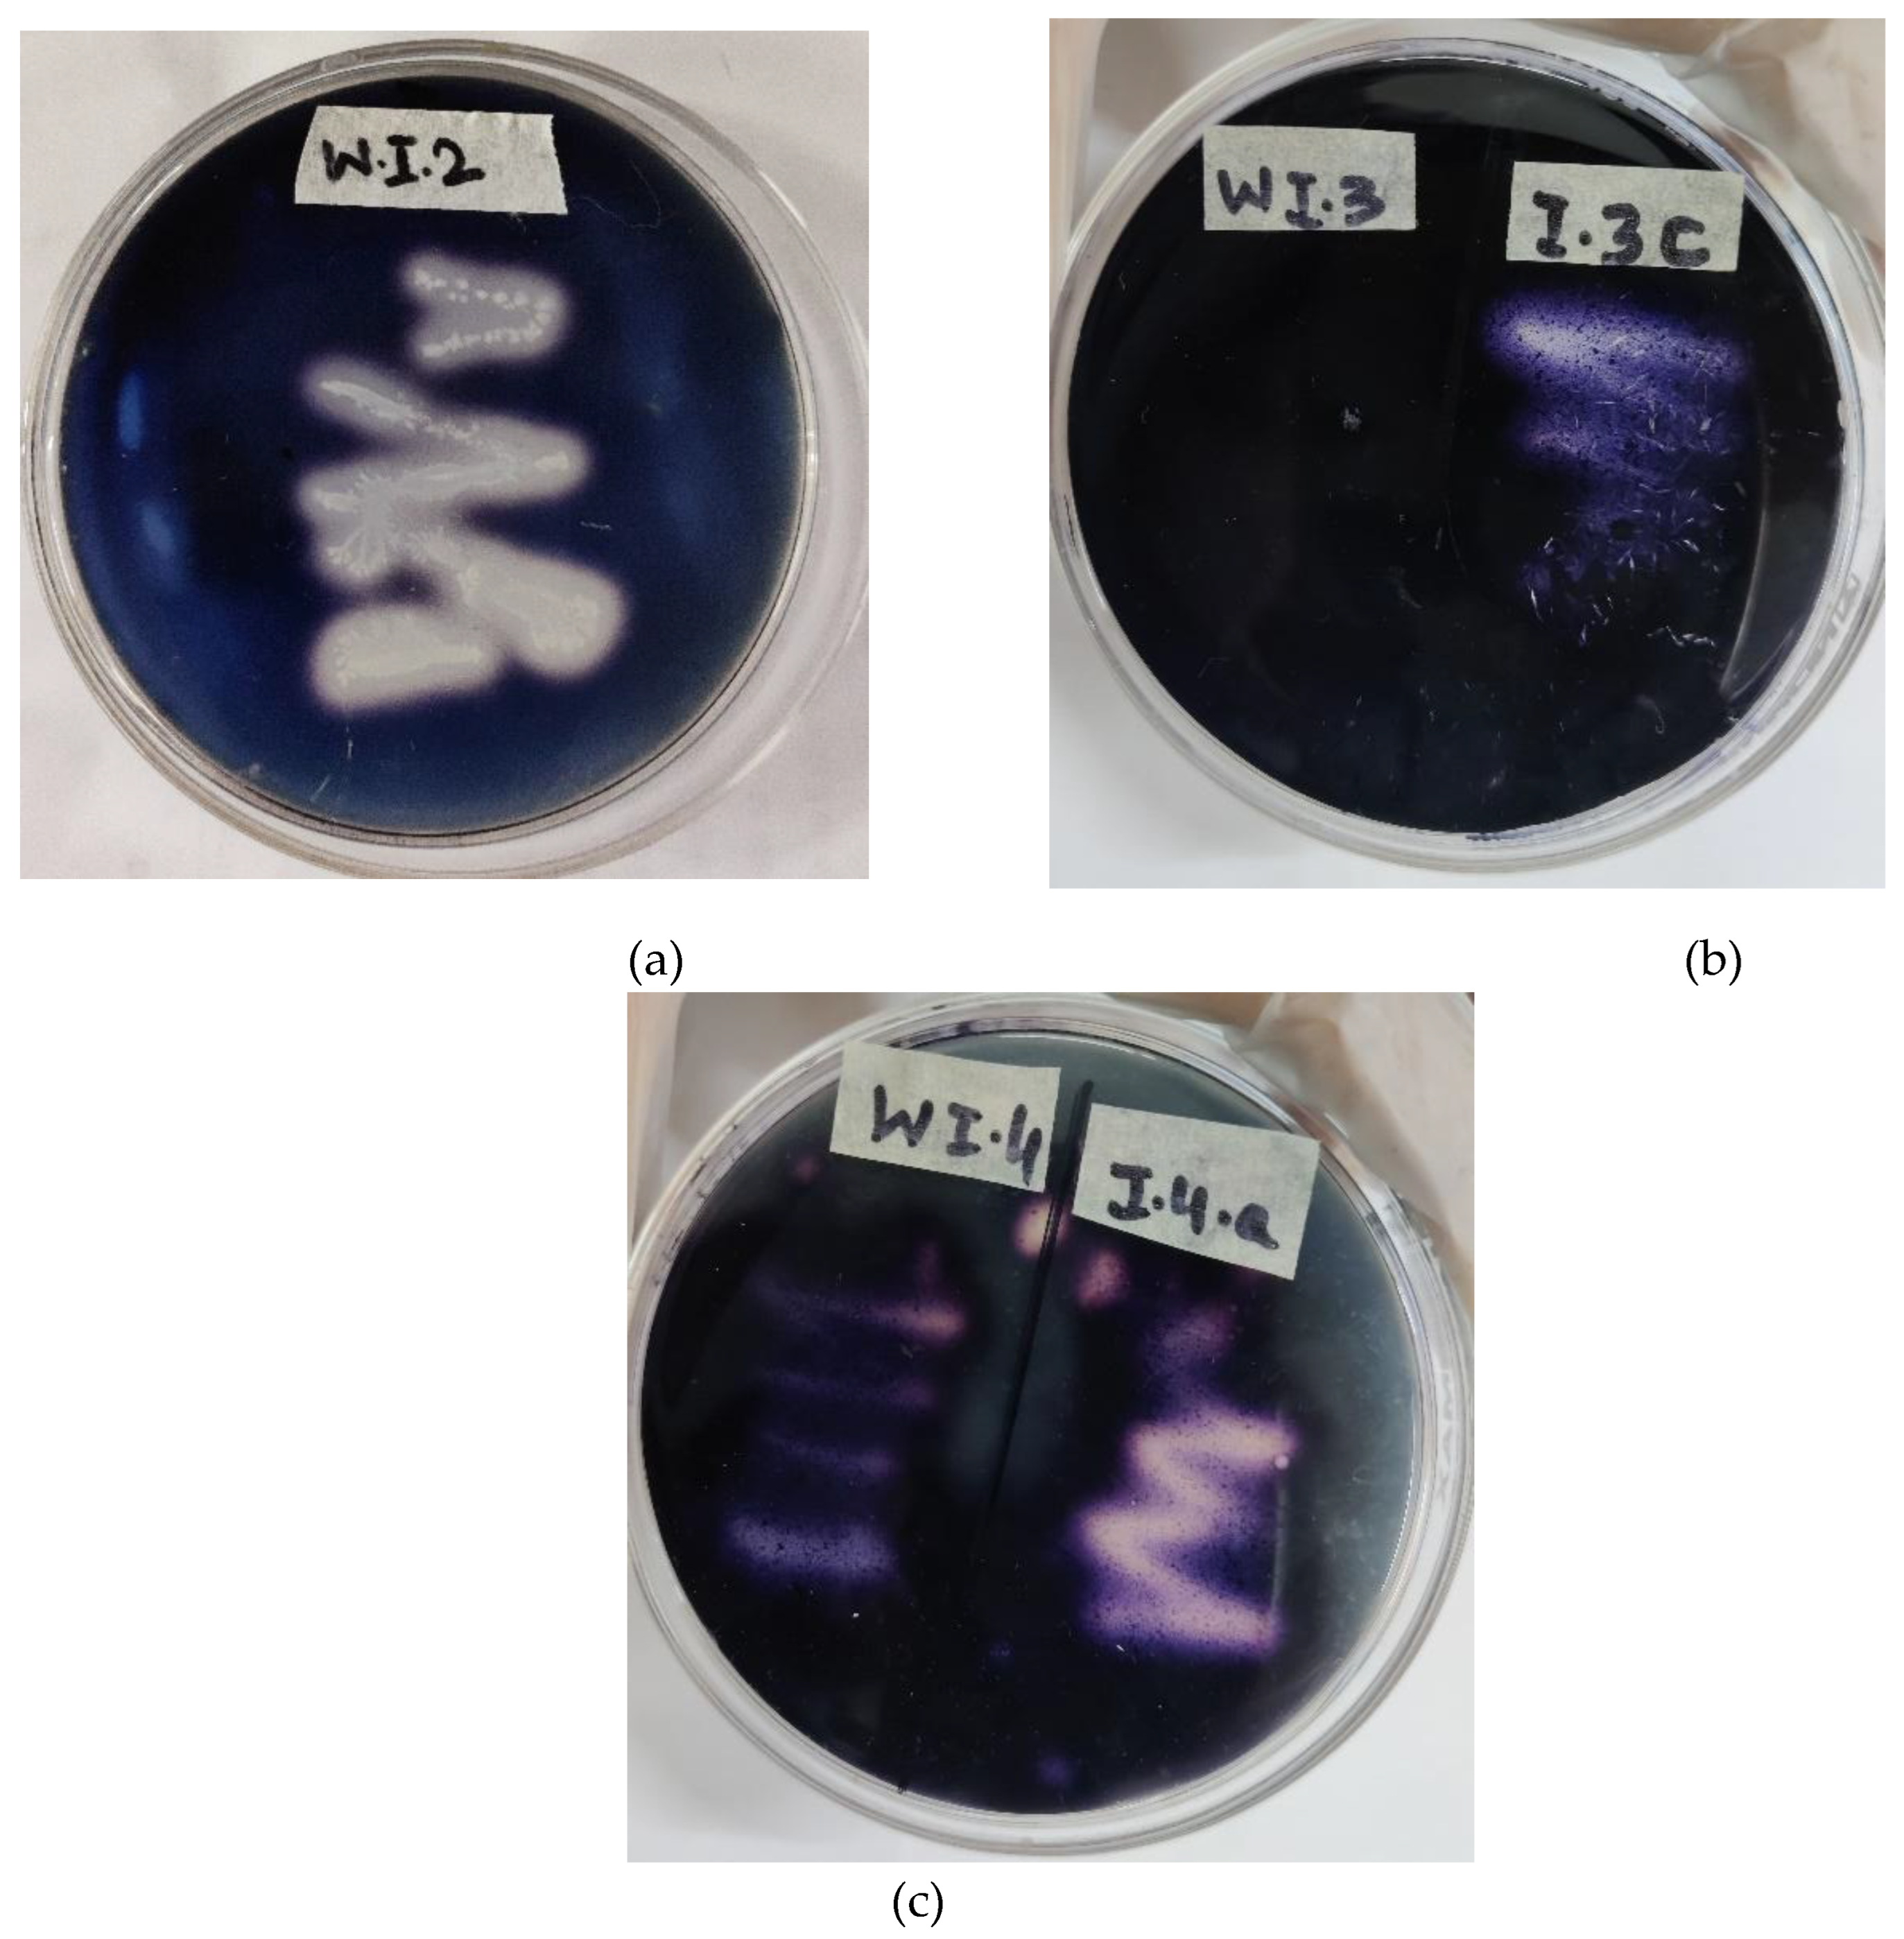
Preprints 170892 g005

1. Introduction
According to the projections of United Nations the world’s population is expected to reach 9.8 billion by 2050. As a result, the average food consumption is also expected to rise per person per day. To meet the increasing food demands, agricultural production needs to be increased by 60% over the next years; which as a result leads to overuse of chemical fertilizers. Chemical fertilizers undoubtedly increases the productivity of agriculture, but it also compromises soil health, decreases bacterial diversity in soil, agricultural sustainability and is a cause of increasing soil and groundwater pollution. The most widely used fertilizer around the world are nitrogen fertilizers, which are also highly susceptible to loss by the process of denitrification and leaching in the fields [
1,
2]. However, the increasing cost of chemical fertilizers during last decades, increase the interest in research of nitrogen fixing bacteria [
3]. Asymbiotic nitrogen fixing bacteria are investigated among the most important organisms contributing towards the soil fertility. The positive effects on plant growth and plant yield using these microbes are reported in many studies [
4]. These bacteria also increases nutrient uptake when inoculated to roots [
5].
Biofertilizers comprises of microscopic living organisms. When applied to seeds, soil or plant surfaces, these microorganisms colonizes rhizosphere and plant interior thus promoting plant growth by different pathways [
2,
6]. This can reduce the use of chemical fertilizers. While considering the sustainable agricultural methods and environmental protection, these microorganisms are reported to use as bio inoculants in order to minimize the use of chemical fertilizers [
7,
8,
9]. Most of the nitrogen fixing microorganisms are present around roots, or in the plant tissues. They fix atmospheric nitrogen which contributes to plant nitrogen content [
10].
Nitrogen fixing endophytic bacteria are able to provide organic nitrogen to plants by biological nitrogen fixation (BNF), which is a significant nitrogen input in agricultural sector and can be used as a promising substitute for chemical nitrogen fertilizers. These endophytes are known as endophytic diazotrophic bacteria [
11]. BNF converts nitrogen in a form which can be used by living organisms for biosynthesis [
12]. Based on the research in sugar cane and palm oil leaves, diazotrophic endophytes had the ability to increase dry weights of plant and its height when compared to non-endophytic diazotrophic bacteria [
9]. Endophytic bacteria colonizes plant tissues and do not showing any cytotoxic effect. However, they maintains a beneficial relation with their host plant by producing required enzymes, mobilization of nutrients and translocation of compounds, such as nitrogen fixation, ammonia (NH3) production, and phosphate solubilization [
13,
14].
Based on the research in sugar cane and palm oil leaves, diazotrophic endophytes had the ability to increase dry weights of plant and its height when compared to non-endophytic diazotrophic bacteria [
15,
16]. However, for selecting isolates being effective in this process. The nitrogen fixing endophytes have to be first selected with preliminary tests. The aim of this research is isolating the bacterial strains which are able to grow in nitrogen-free minimal growth medium from wheat plant. These strains can be used as nitrogen fixing biofertilizers. 16S rRNA sequencing of the selected strains with biotechnological potential has been used to identify genera of isolated endophytic diazotrophic bacteria.
2. Materials and Methods
2.1. Plant Sampling
Wheat seed of industrial quality were used in this research. Wheat seeds were surface sterilized with sterile distilled water, 70% ethanol, 2.5% sodium hypochlorite followed by final rinsing with sterile distilled water. Seeds were sowed in plastic pots and plants were harvested after 5–6 weeks of growth. From each plant, the first few leaves from a tip of shoots were excised and washed with tap water.
2.2. Isolation of bacterial endophytes
Excised leaves were sterilized by soaking the tissues in sterile distilled water followed by dipping in 70% ethanol and 2.5% sodium hypochlorite. Leaved were again soaked in 70% ethanol and a series of rinsing was performed in sterile distilled water. 0.1 mL from the final rinse solution was spread on sterile nutrient agar plates to check the sterilization of leaves.
A segment of sterilized leaves was crushed in sterilized saline solution using pestle and mortar. 1 ml from the suspension was serially diluted until 10-3. For the isolation of bacterial endophytes, 0.1 mL aliquot from 10-3 dilution was spread onto petri plates containing nutrient agar medium. The plates were then incubated at 35◦C ± 2 for 24 to 48 hours [
14,
17,
18,
19]. Bacterial colonies were selected on the basis of their morphological characteristics. Individual colonies were sub-cultured on nutrient agar plates for further screening.
2.3. Screening of Nitrogen Fixers
Nitrogen fixing endophytes were qualitatively selected using Nitrogen free Bromothymol blue Medium. Isolates were inoculated in Nutrient Broth (NB) for 24 h at 35◦C ± 2. 1 ml from the bacterial cultures were then be introduced into Mannitol NfB semi solid medium and incubated for 3 to 7 days at 35◦C ± 2. The change of color in the medium and pellicle formation was observed and recorded [
9,
10,
20]. After characteristic pellicle formation, a loop from the pellicle is inoculated onto the similar minimal solid medium. The pure isolates were then transferred to nutrient agar plates.
Nitrogen-free bromothymol blue mineral medium (NfB): The medium composition was as follows (g/L): mannitol 10, K2HPO4 0.75 g, MgSO4·7H2O 0.5 g, CaCO3 3.0 g, Na2MoO4·2H2O 0.02 g. for semi-solid medium, a total of 1.6 to 1.80 g/l agar should be added. 15 g/l agar for the solid medium. Various ingredients were added in the provided sequence to avoid the precipitation of salts [
10,
20,
21]. Working solution of Bromothymol blue was prepared in KOH (5 g/l in 0.2 M KOH) [
20,
22].
2.4. Quantitative Selection with Nessler’s Reagent
The selected bacteria for nitrogen fixation ability were grown on NB media at 35◦C ± 2 for 24 hours. The culture were centrifuged at 4000 rpm for about 10 minutes. In a test tube, 60 μl of Rochelle salt (Potassium sodium tartrate) and 60 μl of Nessler’s reagent was added to 2 ml of culture supernatant and incubated for 30 minutes. The solution exhibiting yellow color in the test tubes indicates the formation of ammonium ions (NH4 +). The formed NH4 + ions were calculated by the help spectrophotometer at a wavelength of 425 nm [
9]. The absorbance of supernatant was then converted to µg/ml with reference to standardized ammonium sulphate (NH₄)₂SO₄ curve.
2.5. Ammonia Production
The selected nitrogen fixing strains were assessed to produce NH3 in 3% peptone water. Bacterial strains were inoculated in 5 ml of peptone water and incubated for 48 to 72 hours at 35◦C ± 2. After incubation 1 ml of Nessler’s reagent was added to the test tubes. Any color change from faint yellow to deep yellow or brown indicates the production of ammonia [
23,
24].
2.6. Screening of Selected Nitrogen Fixing Strains for Enzymatic Activity
Selected strains were screened for urease and amylase activity. Urease activity was determined by inoculating 5 ml of urease broth with 0.1 ml of bacterial cultures. The test tubes were incubated at 30◦C for 24 to 48 hours. Color change from yellow to purple pink indicates urease activity. For amylase activity, isolates were inoculated on sterile starch agar plates and incubated at 30◦C for 5 days. The plates were then flooded with Lugol’s iodine [
24]. Clear zone formation around the bacterial growth indicates positive results.
2.7. Molecular Identification of Bacterial Strains
Bacterial identification was performed on the basis of 16S ribosomal RNA (16S rRNA) gene sequence analysis. Genomic DNA of selected isolates was extracted by the method described by Miller et al.[
25] with few modifications. Briefly, isolated colonies from nutrient agar plate were selected with a sterilized loop and re-suspended in sterile deionized water. Cell suspension was incubated in a water bath for 10 minutes at 97°C. The resulted cell lysate was centrifuged at 15,000x g for 10 minutes. The DNA was then recovered from the supernatant. The concentration of extracted DNA was determined by its absorbance at the wavelength of 260 nm in a spectrophotometer.
A partial fragment of 16S rDNA was amplified using the bacterial universal primers 27F 5’ (AGA GTT TGA TCM TGG CTC AG) 3’ and 1492R 5’ (TAC GGY TAC CTT GTT ACG ACT T) 3’ (The PCR reaction contained: 1 x PCR buffer, 0.5 mM MgCl2, 2.5 U Taq DNA polymerase (QIAGEN), 0.25 mM dNTP, 0.5 µM of each primer, and approximately 5 ng of bacterial genomic DNA. The 16S PCR cycling conditions were initial denaturation at 94 °C for 5 min, followed by 35 cycles of denaturing at 94 °C for 30 sec, annealing at 52.7 °C for 35 sec, and extension at 72 °C for 2 min, following a final extension performed at 72 °C for 5 min.).
For sequencing following primers were used 785F 5’ (GGA TTA GAT ACC CTG GTA)3’ and 907R 5’ (CCG TCA ATT CMT TTR AGT TT) 3’. During sequence analysis the following software and data bank were applied. BioEdit, NCBI, BLAST (Basic Local Alignment Search Tool) and MEGAX software to find the Evolutionary relationship to other species based on Distance tree (Fast Minimum Evolution Method, Max Sequence difference 0.75) analysis.
2.8. Statistical Analysis
The data were analyzed through one-way ANOVA using Statistix software (version 9.0). The significance between the means of different treatments was compared by least significant difference tests at the 95% confidence level. All the experiments were performed in triplicates to verify the accuracy and reproducibility of the results.
3. Results
3.1. Isolation of bacterial endophytes
Eleven types of isolates were obtained from the sterile crushed wheat leave samples by the method of serial dilution based on the morphological characteristics of bacteria (
Figure 1). These morphological properties of isolates selected for further investigation was shown in
Table 1.
3.2. Screening of nitrogen fixing endophytic bacteria
Eleven bacterial isolates were inoculated in a semi-solid NfB medium (
Figure 2). In this qualitative test, out of 11 endophytic bacteria, eight isolates forms pellicle on the surface of media. Three isolates showed the distinctive color change of the medium to yellow from blue (
Figure 2b). The pellicle formation and medium discoloration from a blue to yellow color was one of characteristics of non-symbiotic nitrogen-blocking (N) bacterial growth and their nitrogenase activity, Isolate 2 (I-2), isolate 3 (I-3) and isolate 4 (I-4) were selected for further investigation.
Bacteria that were able to grow on nitrogen-free culture media secreted organic acids which caused media discoloration. Moreover, the semi-solid medium allowed non-symbiotic nitrogen-fixers to survive at low partial pressures of O
2 which is favorable for the bacterium during nitrogen fixation. The isolates forming characteristic bacterial pellicles and discoloration in the vials were isolated and transferred to freshly prepared N-free solid medium (
Figure 3).
3.3. Quantitative analysis of nitrogen fixation capability with Nessler’s reagent
All the eleven isolates were selected for quantitative analysis of nitrogen fixation capability. From the (NH₄)₂SO₄ standard curve, NH
3 concentration in each sample was determined (
Table 2). Based on collected data, it is known that the highest level of nitrogen fixation was measured in I-2, I-3 and I-4; also exhibiting distinctive color change in NfB semi-solid medium. In accordance with the qualitative tests indicating that these isolates had the ability to effectively fix nitrogen presented in
Figure 4. Out of eleven, three isolates were selected for further investigation.
3.3. Screening of selected nitrogen fixing strains for enzymatic activity
I-2, I-3 and I-4 were tested for the production of amylase and urease enzyme. I-2 and I-4 produced clear zones when flooded with Lugol’s iodine. Whereas, I-3 did not show any clear zone formation, which suggest that I-3 was not producing amylase enzyme (
Figure 5).
All the isolates were negative for urease activity. There was no color change in urea broth to purple red, indicating no alkalization and urea hydrolysis (
Figure 6).
3.4. Molecular Identification of Bacterial Strains
BLAST and phylogenetic tree analysis of given sequences revealed that all the three isolates have high similarity with various species of Bacillus. Gene sequence from I-2 demonstrated that it highly matches with
B. pumilus and
B. altitudinis (
Figure 7).
BLAST analysis of I-3 represented that it has 96.5% similarity with
Bacillus safensis. Moreover, related sequences of
B. pumilus and
Bacillus sp. within
Firmicutes were also identified. The results suggested that the provided sequence of I-3 belonged to
B. safensis or related species of Bacillus (
Figure 8).
I-4 also exhibited nitrogenase activity when grown in semi-solid NfB medium. Its phylogentic tree analysis also represented that it has the high similarity to
Bacillus sp. More likely related to
B. spizizenii or
B. subtilis (
Figure 9).
4. Discussion
The research study is focused on isolating and identifying nitrogen fixing endophytes. The endophytic bacteria used in this study were isolated from wheat plant. The isolates were tested for their ability to serve as potential biofertilizers, thus minimizing the use of urea. Eleven endophytes were isolated from wheat plant samples. This demonstrates that the microorganism especially bacteria had known for association with plant rhizosphere as well as their internal tissues. The association of these microbes with plants suggests their potential role in improving plant growth. This can be done by facilitating the process of nitrogen fixation and producing other metabolites. After isolating endophytes, initial screening for nitrogen fixing bacteria is performed by growing these eleven isolates in nitrogen free medium. Their growth in this medium confirmed their ability to grow in nitrogen-deficient environment and their nitrogen-fixing capability. Here, semi-solid growth medium is used. The basic principle to use semi-solid medium is that it facilitates the bacteria to grow in a condition where the oxygen level is low. Nitrogenase enzymes is oxygen sensitive. So by keeping the media semi-solid the bacteria grown near the surface forming a thin pellicle thus providing their nitrogenase enzyme protection from denaturation. In the start of the lag phase a small number of bacteria starts to divide which as a result uses very small amount of oxygen. Later in this phase the bacteria migrates close to surface where they find enough O2 pressure.
Further, the bacteria were quantitatively selected by using Nessler’s reagent method. This provided the ammonia producing capabilities of the selected isolates. The documented variations in amount of ammonia produced by the strains exhibited their diverse potential towards nitrogen fixation. This represented their genetic diversity, physiological variations, and environmental adaptability of bacterial species. Nessler’s reagent is a strong alkali, when it reacted with the ammonia present in the bacteria culture it formed a mercury amido-iodide which is a yellow colored product. On higher concentration of ammonia formed, this changes to a brown colored precipitation. The strains demonstrating more color change high were selected for further analysis. Peptone water contains nitrogen source in the form of peptone. Some microbes’ forms ammonia by ammonification and deamination of peptones releasing ammonium ions or ammonia. Also it do not have any carbohydrates in it, which eliminates the possibility of acid production and making ammonia detection easier.
Screening of nitrogen fixing bacteria for amylase and urease activity was important to understand their importance in plant metabolism. The isolated bacterial strains were urease negative, which also supported their nitrogen fixing ability atmospheric nitrogen without utilizing urea. Previous studies also suggested that urease negative strains contributed to soil nitrogen enrichment, independent of urea hydrolysis. Such microbes likely depends on other atmospheric nitrogen sources for their metabolic activity, and ammonium secretion. Amylases enzyme degrades starch into small sugars. Strains that produced amylase, can effectively utilizes plant root exudates which leads to enhanced nutrient availability in rhizosphere and plant-microbe interactions. Moreover, their amylase degrading ability make them more valuable for improved plant growth.
Molecular identification using 16S rRNA sequencing method of the selected isolates confirmed their taxonomic classification. Their phylogenetic analysis exhibited that all the selected isolates had a relationship with bacillus species. Members of bacillus genus had been previously reported for their N2 fixing capability, as they can provide N2 to the host plants. The findings of the presented research work aligns with the previous studies reporting that the nitrogen-fixing endophytes are present in variety of plants, and can serve as biofertilizers. The identification of Bacillus sp. reinforces the potential application of these strains in sustainable agriculture. Not only by promoting plant growth but also reducing the dependency of chemical fertilizers.
By harnessing their natural abilities, agricultural sector can apply eco-friendly agricultural procedures that reduces chemical inputs and their related harmful effects. Moreover, cost-effective techniques for nutrient management can also be achieved. Future research aspects, including pot plant and field study is required for the optimization of their uses as biofertilizers. Further studies should also focus on the formulations of microbial consortia to study their synergistic effects in order to boost nitrogen fixation and improved plant growth in different environmental conditions. The documented results of this research from plant sampling to bacterial isolation, screening of nitrogen fixers and their molecular identification provide valued insights into efficient and potential uses of these bacteria.
5. Conclusions
In this research study, nitrogen-fixing endophytic bacteria were successfully isolated on nitrogen free semi-solid and solid mannitol medium from wheat plant. Molecular identification of highest ammonia producing strains was performed which depicts that Bacillus pumilus and Bacillus safiensis can potentially be used as effective biofertilizers to minimize the effect of urea on environment. The quantitative screening method using Nessler’s reagent provided valued insights into the nitrogen-fixing capabilities of the isolates. The findings of the conducted research suggested that wheat-associated Bacillus species especially B. pumilus could serve as promising candidate in enhancing soil fertility thus minimizing the dependency on chemical nitrogen fertilizers. Further studies, including in-planta experiments and field experiments, are recommended to authenticate their efficiency in enhancing plant growth and improving sustainable agricultural practices.
Author Contributions
Conceptualization, Z.H. and W.N.; methodology, W.N. and Z.H.; software, T.u.H. and F.A.; validation, W.N., Z.H., F.A. and T.u.H.; formal analysis, Z.H., F.A. and T.u.H.; investigation, W.N.; resources, W.N. and Z.H.; data curation, W.N.; writing—original draft preparation, W.N.; writing—review and editing, W.N.AND T.u.H; visualization, W.N.; supervision, Z.H.; project administration, W.N. and Z.H.; funding acquisition, W.N. All authors have read and agreed to the published version of the manuscript.
Funding
This research received no external funding.
Data Availability Statement
Acknowledgments
In this section, you can acknowledge any support given which is not covered by the author contribution or funding sections. This may include administrative and technical support, or donations in kind (e.g., materials used for experiments). Where GenAI has been used for purposes such as generating text, data, or graphics, or for study design, data collection, analysis, or interpretation of data, please add “During the preparation of this manuscript/study, the author(s) used [tool name, version information] for the purposes of [description of use]. The authors have reviewed and edited the output and take full responsibility for the content of this publication.”
Conflicts of Interest
Declare conflicts of interest or state “The authors declare no conflicts of interest.” Authors must identify and declare any personal circumstances or interest that may be perceived as inappropriately influencing the representation or interpretation of reported research results. Any role of the funders in the design of the study; in the collection, analyses or interpretation of data; in the writing of the manuscript; or in the decision to publish the results must be declared in this section. If there is no role, please state “The funders had no role in the design of the study; in the collection, analyses, or interpretation of data; in the writing of the manuscript; or in the decision to publish the results”.
Abbreviations
The following abbreviations are used in this manuscript:
| BNF |
Biological nitrogen fixation |
| NH3
|
Ammonia |
| NB |
Nutrient broth |
| NfB |
Nitrogen free bromothymol blue |
| NH4+ |
Ammonium ion |
| 16S rRNA |
16S ribosomal RNA |
| NfB |
|
References
- Majeed A, Abbasi MK, Hameed S, Imran A, Rahim N. Isolation and characterization of plant growth-promoting rhizobacteria from wheat rhizosphere and their effect on plant growth promotion. Front Microbiol. 2015. 6, 1–10. [CrossRef]
- Rosenblueth M, Ormeño-Orrillo E, López-López A, Rogel MA, Reyes-Hernández BJ. et al. Nitrogen Fixation in Cereals. Front Microbiol. 2018. 6, 1–13. [CrossRef]
- Benedetto NA, Corbo MR, Campaniello D, Cataldi MP, Bevilacqua A, et al. The role of Plant Growth Promoting Bacteria in improving nitrogen use efficiency for sustainable crop production: a focus on wheat. AIMS Microbiol; 2017. 3, 413-434. [CrossRef]
- Soliman, S, Aly SSM, Gadalla A M, Abou Seeda M. Nitrogen fixed by wheat plants as affected by nitrogen fertilizer levels and Non-symbiotic bacteria. 1995. 833-843.
- Tsegaye Z, Alemu T, Desta FA, Assefa F. Plant growth-promoting rhizobacterial inoculation to improve growth, yield, and grain nutrient uptake of teff varieties. Front Microbiol 2022. 13, 1-9. [CrossRef]
- Singh, R.K., Singh, P., Li, HB. et al. Diversity of nitrogen-fixing rhizobacteria associated with sugarcane: a comprehensive study of plant-microbe interactions for growth enhancement in Saccharum spp.. BMC Plant Biol. 2020. 20, 1-21. [CrossRef]
- ‘Szilagyi-Zecchin VJ, Ikeda AC, Hungria M, Adamoski D, Kava-Cordeiro V, Glienke C, Galli-Terasawa LV. Identification and characterization of endophytic bacteria from corn (Zea mays L.) roots with biotechnological potential in agriculture. AMB Express. 2014. 7, 4:26. [CrossRef]
- Goswami, D., Parmar, S., Vaghela, H., Dhandhukia, P., & Thakker, J. N. Describing Paenibacillus mucilaginosus strain N3 as an efficient plant growth promoting rhizobacteria (PGPR). Cogent food agric. 2015. 1, 1-13. [CrossRef]
- Aryantha, I. N. P and Hidiyah, A.R.M. Colonization and Performance of Diazotroph Endophytic Bacteria on Palm Oil (Elaeis guineensis Jacq L.) Leaves IOP Conf. Ser.: Earth Environ. Sci. 2018. 166, 1-13. [CrossRef]
- Yu, S. S., Latt Z. K., Kyaw E. P. and Ly T. M. Accumulation of ammonia in culture broth by wild-type nitrogen-fixing bacterium, stenotrophomonas maltophilia. Int. J. Appl. Biol. Pharm. 2011. 2, 72-77. [CrossRef]
- Imran Afzal, Zabta Khan Shinwari, Shomaila Sikandar, Shaheen Shahzad. Plant beneficial endophytic bacteria: Mechanisms, diversity, host range and genetic determinants, Microbiol. Res., 2019. 221, 36-49. [CrossRef]
- Soumare A, Diedhiou AG, Thuita M, Hafidi M, Ouhdouch Y, Gopalakrishnan S, Kouisni L. Exploiting Biological Nitrogen Fixation: A Route Towards a Sustainable Agriculture. Plants. Basel. 2020. 9, 1-22. [CrossRef]
- Silva, k. D., Nobrega, R. S. A., Lima, A. S., Barberi, A. and Moreira, F. M. D. S. Density and diversity of diazotrophic bacteria isolated from Amazonian soils using N-free semi-solid media. Sci. Agric. 2011. 68, 518-525. [CrossRef]
- ALKahtani, M.D.F.; Fouda, A.; Attia, K.A.; Al-Otaibi, F.; Eid, A.M.; Ewais, E.E.-D.; Hijri, M.; St-Arnaud, M.; Hassan, S.E.-D.; Khan, N. . Isolation and Characterization of Plant Growth Promoting Endophytic Bacteria from Desert Plants and Their Application as Bioinoculants for Sustainable Agriculture. Agronomy; 2020. 10, 1325. [CrossRef]
- Keyser, H. H. and Li, F. 1992. Potential for increasing biological nitrogen fixation in soybean Plant and soil. 1992. 141, 119-135. [CrossRef]
- Fouda, A.; Eid, A.M.; Elsaied, A.; El-Belely, E.F.; Barghoth, M.G.; Azab, E.; Gobouri, A.A.; Hassan, S.E.-D. Plant Growth-Promoting Endophytic Bacterial Community Inhabiting the Leaves of Pulicaria incisa (Lam.) DC Inherent to Arid Regions. Plants 2021. 10, 1-22. [CrossRef]
- Khalil AMA, Hassan SE, Alsharif SM, Eid AM, Ewais EE, Azab E, Gobouri AA, Elkelish A, Fouda A. Isolation and Characterization of Fungal Endophytes Isolated from Medicinal Plant Ephedra pachyclada as Plant Growth-Promoting. Biomolecules.2021. 11, 1-19. [CrossRef]
- Bahodir Mamarasulov, Kakhramon Davranov, Mohammad Shah Jahan, Dilfuza Jabborova, Omaima Nasif, Mohammad Javed Ansari, Subhan Danish, Rahul Datta. Characterization, enzymatic and biochemical properties of endophytic bacterial strains of the medicinal plant Ajuga turkestanica (Rgl.) Brig (Lamiaceae), J. King Saud Univ. Sci. 2022. 34, 1-9. [CrossRef]
- Renugadevi R, Ayyappadas M. P, Mahesh M, Kiruba M, Arunkumar M. Nitrogen Fixing Activity of Endophytic Bacteria Associated with Kalanchoe pinnata (Lam.) and its effect on Zea mays. Biotech Res Asia. 2024. 21, 163-174 . [CrossRef]
- Baldani, J. I., Reis, V. M., Videira, S. S., Boddey, L. H., & Baldani, V. L. D. The art of isolating nitrogen-fixing bacteria from non-leguminous plants using N-free semi-solid media: a practical guide for microbiologists. Plant and Soil. 2014. 384, 413–431. [CrossRef]
- Kifle MH, Laing MD.. Isolation and Screening of Bacteria for Their Diazotrophic Potential and Their Influence on Growth Promotion of Maize Seedlings in Greenhouses. Front Plant Sci. 2016. [CrossRef]
- Satapute, P. P., Olekar, H. S., Shetti, A. A., Kulkarni, A. G., Hiremath, G. B., Patagundi, B. I., Shivsharan, C. T and Kaliwal, B. B. isolation and characterization of nitrogen fixing Bacillus subtilis strain AS-4 from agricultural soil. Int. J. Recent Sci. Res. 2012. 3.
- Farah Ahmad, Iqbal Ahmad, M.S. Khan. Screening of free-living rhizospheric bacteria for their multiple plant growth promoting activities. Microbiol. Res. 2008. 163, 173-181. [CrossRef]
- Arora, S., Patel, P. N., Vanza, M. J., Rao, G. G.. Isolation and characterization of endophytic bacteria colonizing halophyte and other salt tolerance plant species from coastal Gujarta. Afr. J. Microb. Res. 2014. 8, 1779–1788. (. [CrossRef]
- Miller, D. N., Bryant, J. E., Madsen, E. L., Ghiorse, W. C. Evaluation and optimization of DNA extraction and purification procedures for soil and sediment samples. Appl. Environ. Microbiol. 1999. 65.
|
Disclaimer/Publisher’s Note: The statements, opinions and data contained in all publications are solely those of the individual author(s) and contributor(s) and not of MDPI and/or the editor(s). MDPI and/or the editor(s) disclaim responsibility for any injury to people or property resulting from any ideas, methods, instructions or products referred to in the content. |
© 2025 by the authors. Licensee MDPI, Basel, Switzerland. This article is an open access article distributed under the terms and conditions of the Creative Commons Attribution (CC BY) license (http://creativecommons.org/licenses/by/4.0/).